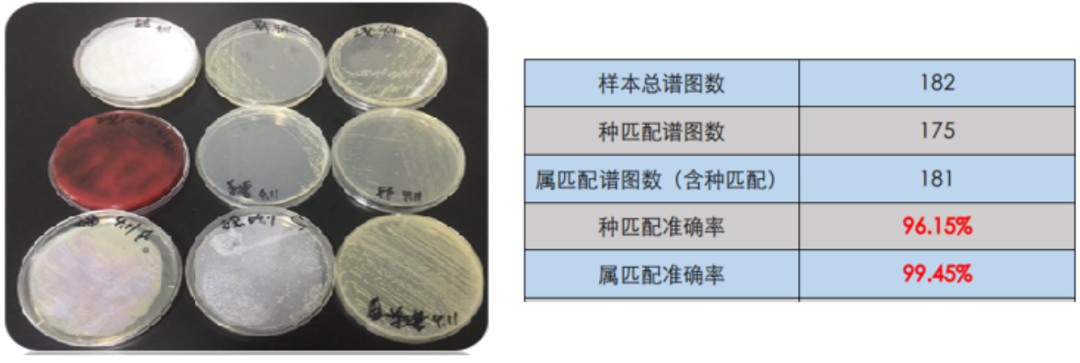

近期,我国遭受持续强降雨的影响,多地发生洪涝灾害。洪涝灾害通常会导致食物受淹、受潮变质以及大量畜禽死亡等问题,严重影响食品供应链的各个环节。
例如生活饮用水和食物受到致病菌、有毒有害物质或次生化学物质的污染,食用了受污染的食物会对人体健康造成严重影响,引发腹泻、痢疾等疾病,甚至可能引发传染性疾病的流行。
为了更好地支持汛期食品安全检测工作,禾信仪器不断完善汛期食品解决方案,为保障汛期食品安全提供有力的科技支持,为广大人民群众的健康保驾护航。


菌种鉴定

全自动微生物质谱检测系统CMI-3800

水质异味分析


真菌毒素检测

三重四极杆液质联用仪LC-TQ 5200

禾信仪器在守护汛期食品安全方面表现出色,凭借先进的质谱技术,有效地检测和分析食品中的有害物质,确保食品的质量和安全。秉持“做中国人的质谱仪器”理念,禾信仪器以创新科技为支撑,为舌尖上的安全保驾护航。
